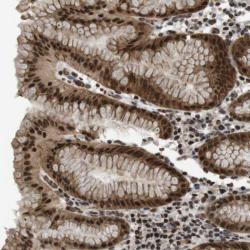

Antibody data
- Antibody Data
- Antigen structure
- References [1]
- Comments [0]
- Validations
- Immunohistochemistry [1]
Submit
Validation data
Reference
Comment
Report error
- Product number
- sc-20096 - Provider product page

- Provider
- Santa Cruz Biotechnology
- Proper citation
- Santa Cruz Biotechnology Cat#sc-20096, RRID:AB_2302524
- Product name
- Anti-SOX11
- Antibody type
- Polyclonal
- Antigen
- Recombinant full-length protein
- Reactivity
- Human
- Host
- Rabbit
Submitted references Sox11 transcription factor modulates peripheral nerve regeneration in adult mice.
Jankowski MP, McIlwrath SL, Jing X, Cornuet PK, Salerno KM, Koerber HR, Albers KM
Brain research 2009 Feb 23;1256:43-54
Brain research 2009 Feb 23;1256:43-54
No comments: Submit comment
Supportive validation
- Submitted by
- per
- Main image
- Experimental details
- Immunohistochemical staining of human stomach shows strong nuclear positivity in glandular cells.
- Validation comment
- Staining pattern partly consistent with experimental and/or bioinformatic data.